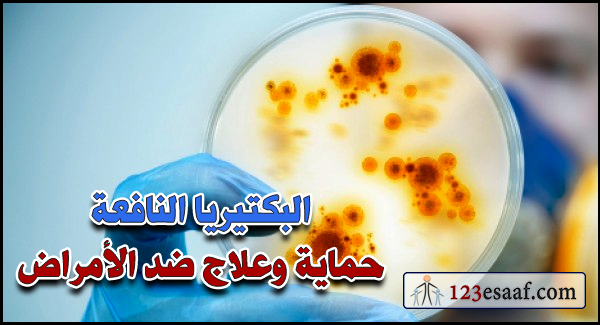
البكتيريا النافعة حماية وعلاج ضد الأمراض

إن حدوث تنميل في اليدين أو القدمين أو كليهما أمر شائع ومزعج جدًا، ويمكن أن يكون ذلك مؤقتًا في بعض الأحيان، لكن يمكن أن يكون تنميل الأطراف مزمنًا نتيجة وجود حالة طبية معينة في كثير من الحالات.
-
أحدث المقالات
البحث فى المقالات
خدمات موقع اسعاف الطبى
الأرشيف
-
روابط
- facebook صفحتنا على الفيس بوك
- facebook group الجروب على الفيس بوك
- twitter تواصل معنا على تويتر